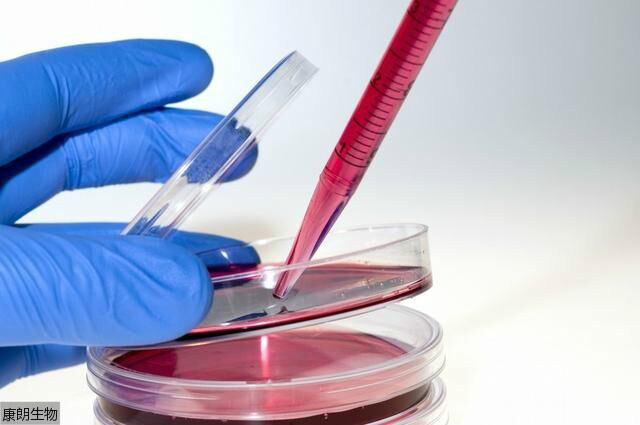

| 细胞类型 | 详见说明书 |
| 肿瘤类型 | 详见说明书 |
| 供应商 | 上海康朗生物科技有限公司 |
| 数量 | 大量 |
| 英文名 | 原代细胞 |
| 生长状态 | 详见说明书 |
| 年限 | 永久 |
| 运输方式 | 干冰或常温 |
| 器官来源 | 详见说明书 |
| 是否是肿瘤细胞 | 详见说明书 |
| 细胞形态 | 详见说明书 |
| 免疫类型 | 详见说明书 |
| 物种来源 | 详见说明书 |
| 相关疾病 | 详见说明书 |
| 组织来源 | 详见说明书 |
| 规格 | 株 |
原理:将动物机体的各种组织从机体中取出,经各种酶(常用胰蛋白酶)、螯合剂(常用EDTA)或机械方法处理,分散成单细胞,置合适的培养基中培养,使细胞得以生存、生长和繁殖,这一过程称原代培养。
仪器、材料及试剂:
仪器:培养箱(调整至37°C),培养瓶、青霉素瓶、小玻璃漏斗、平皿、吸管、移液管、纱布、手术器械、血球计数板、离心机、水浴箱(37°C)
材料:动物组织块
试剂:1640培养基(含20%小牛血清),0.25%胰酶,Hank′s液,碘酒
初代消化培养法:
准备:取各种已消毒的培养用品置于净化台面,紫外线消毒20分钟。开始工作前先洗手、75%酒精擦拭手至肘部。
布局:点燃酒精灯,安装吸管帽。
处理组织:把组织块置于烧杯中,用Hanks液漂洗2~3次,去除血污;如怀疑组织可能污染,可先置于含有青链霉素的混合液中30~60分钟。
剪切:用眼科剪把组织切成2~3毫米大小的块,以便于消化。加入比组织块总量多30~50倍的胰蛋白酶液,然后一并倒入三角烧瓶中,结扎瓶口或塞以胶塞。
消化:或用恒温水浴,或置于37°C温箱消化均可,消化中每隔20分钟应摇动一次,如用电磁恒温搅拌器消化更好。消化时间依组织块的大小和组织的硬度而定。
分离:在消化过程中见消化液发混浊时,可用吸管吸出少许消化液在镜下观察,如组织已分散成细胞团或单个细胞,立即终止消化,随即通过适宜不锈钢筛,滤掉尚未充分消化开的组织块。低速(500~1000转/分)离心消化液5分钟,吸出上清,加入适量含有血清的培养液。
计数:用计数板计数,如细胞悬液细胞密度过大,再补加培养液调整后,分装入培养瓶中。对大多数细胞来说,pH要求在7.2~7.4范围,培养液呈微红色,如颜色偏黄,说明液体变酸,可用NaHCO3调整。
培养:置于36.5°C温箱培养,如用CO2温箱培养,瓶口需用纱布棉塞或螺旋帽堵塞,纱布塞易生霉菌,每次换液时需要换新塞。
初代组织块培养法
剪切:把组织小块置于小烧杯或青霉素小瓶中,用Hanks液漂洗二三次以去掉表面血污,吸静Hanks液,用眼科剪反复剪切1mm3块为止。
摆布:用弯头吸管吸取若干小块,置于培养瓶中,用吸管弯头把组织小块摆布在培养瓶底部,小块相互距离以0.5cm为宜,每一25ml培养瓶底可摆布20~30块。
轻轻翻转培养瓶,另瓶底向上,注意翻瓶时勿另组织小块流动,塞好瓶塞,置36.5°C温箱培养2小时左右(勿超过4小时),使小块微干涸。
培养:从微箱中取出培养瓶,开塞,46度斜持培养瓶,箱瓶底脚部轻轻注入培养液少许,然后缓缓再把培养瓶翻转过来,让培养液慢慢覆盖附于瓶地上的组织小块。置温箱中静止培养。待细胞从组织块游出数量增多后。再补加培养液。

原理:细胞在培养瓶长成致密单层后,已基本上饱和,为使细胞能继续生长,同时也将细胞数量扩大,就必须进行传代(再培养)。传代培养也是一种将细胞种保存下去的方法。同时也是利用培养细胞进行各种实验的必经过程。悬浮型细胞直接分瓶就可以,而贴壁细胞需经消化后才能分瓶。
材料和试剂
1. 细胞:贴壁细胞株
2. 试剂:0.25%胰酶、1640培养基(含10%小牛血清)。
3. 仪器和器材:倒置显微镜,培养箱、培养瓶、吸管、废液缸等。
操作步骤
1. 吸除培养瓶内旧培养液;
2. 向瓶内加入胰蛋白酶和EDTA混合液少许,以能覆满瓶底为限;
3. 置温箱中2~5分钟,当发现细胞质回缩,细胞间隙增大后,立即终止消化;
4. 吸除消化液,向瓶内注入Hanks液数毫升,轻轻转动培养瓶,把残余消化液冲掉。注意加Hanks液冲洗细胞时,动作要轻,以免把已松动的细胞冲掉流失,如用胰蛋白酶液单独消化,吸除胰蛋白酶液后,可不用Hanks液冲洗,直接加入培养液;
5. 用吸管吸取营养液轻轻反复吹打瓶壁细胞,使之从瓶壁脱离形成细胞悬液;
6. 计数板计数后,把细胞悬液分成等份分装入数个培养瓶中,置温箱中培养。

无菌操作注意事项
1. 操作前要洗手,进入超净台后手要用75%酒精或0.2%新洁尔灭擦试,试剂等瓶口也要擦拭;
2. 点燃酒精灯,操作在火焰附近进行,耐热物品要经常在火焰上烧灼,金属器械烧灼时间不能太长,以免退火,并冷却后才能夹取组织,吸取过营养液的用具不能再烧灼,以免烧焦形成碳膜;
3. 操作动作要准确敏捷,但又不能太快,以防空气流动,增加污染机会;
4. 不能用手触已消毒器皿的工作部分,工作台面上用品要布局合理;
5. 瓶子开口后要尽量保持45°C斜位;
6. 吸溶液的吸管等不能混用。